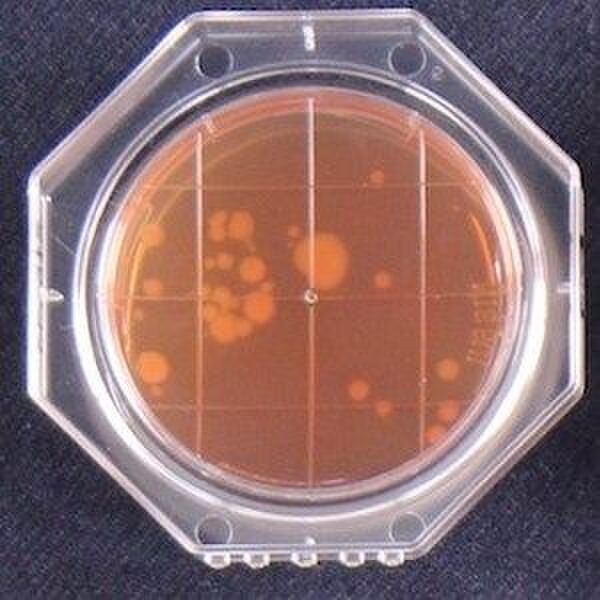
知らないうちに大腸菌があそこにも、ここにも!!
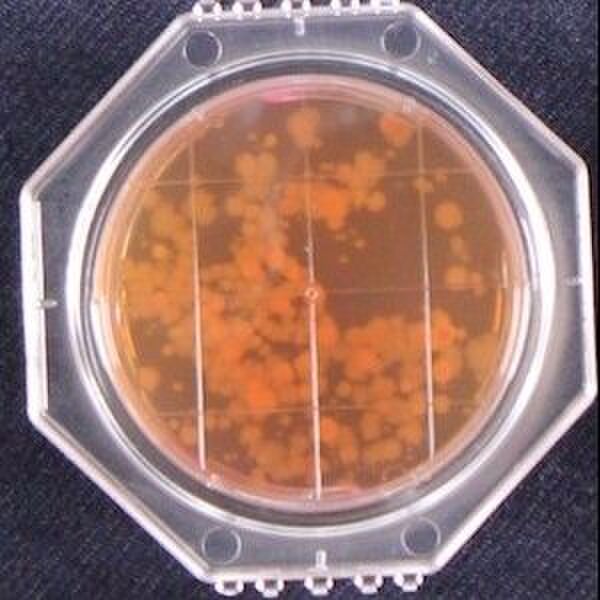

20~50代の女性11名に同じレシピの調理を行ってもらい、すべて終わったあとに、調理器具や食器、調味料、タオルキッチン小物などに付着している大腸菌群を調べました。
<調理したメニュー>
・豚バラ肉ともやしの炒め物
・レタスときゅうりの野菜サラダ
<調理の流れ>
①炒め用の食材(もやし、ニラ、豚バラ肉)を袋やパックから取り出す
②食材を包丁で切る
③切った食材をフライパンに入れる
④フライパンで炒める(炒め物のできあがり)
⑤ボウルを使ってレタスを洗い、手でちぎる
⑥サラダを盛り付ける
※調理中の手洗いは特に指示せず、普段どおりに行ってもらっています。
調べてみると、かなりコワ~い結果が! 包丁やフライパンの持ち手、ボウルのふちなど、半数以上から大腸菌群が検出されたんです。
上の写真は包丁の柄の部分で、11人中7人から検出!
ボウルのふち部分には大腸菌群がこんなにいっぱい!11人中9人から検出されました。

さらに、調理したあとの手から大腸菌群が検出された例も。
写真左は調理前(ハンドソープで手洗いしたあと)で大腸菌群がない状態。 右の写真が調理後です。大腸菌群(赤い点々)が手のひら全体に広がっているのがわかりますね。
実験に参加したかたは、みなさん調理中に手洗いをしていました。それなのに、なぜこのような結果になったのでしょうか?
そこで、実験中の調理行動を改めて観察し、どのタイミングで手洗いを行っているかチェック。その結果、きちんと手洗いをしているつもりでも、実は「見落としがちな手洗いのタイミング」が2つあることがわかりました。

1.食材を容器から取り出したあと
袋やパックから食材を取り出したあと、ほとんどの人が手洗いをしていませんでした。食材に付着している菌が手に移り、さらに食材を切ったり洗ったりするとき、その手から包丁の柄やボウルに菌が移ってしまったようです。
2.食材をフライパンに移したあと
食材を切るなどの下ごしらえをしたあとは、ほとんどの人がハンドソープを使って手を洗っていましたが、その食材をフライパンに入れた後に手を洗った人はあまりいませんでした。
また、使用した調理用具を洗う時も、改めて手を洗う人はゼロ。つまり、汚れた手のままフライパンを扱ったり、できあがった料理を盛りつけていたんです。
これでは調理器具に菌がついてしまっても仕方ありませんよね。途中で手を洗っていても、汚れた調理器具を触ることで再び手に菌が移り、その手で盛りつけなどをしてしまうと、体内に菌が入ってしまうおそれがあるんです。
肝心なのは、この2つのタイミングに注意しながら、加熱が必要な食材を触ったらしっかり手を洗うということ。
水洗いだけでは、手に付着した菌をきちんと落とすことはできないので、ハンドソープや石鹸できちんと洗いましょう。
ほかにも、生で食べる食材の下ごしらえは最初にする、鍋やフライパンに食材を入れる時はさいばしを使う、調理器具は柄や持ち手までしっかり洗う、などの工夫も効果的。ごはんをおいしく安心して食べられるかどうかは、ママの手にかかっています。毎日の調理で、ぜひ手洗いの習慣をつけて!

Lideaではこの他にも、暑い時期に気になる除菌情報を発信しています。こちらも合わせてご覧ください!!
キッチンの衛生!まな板・包丁の「除菌」方法
https://lidea.today/articles/146

食中毒の予防になる!見落としがちな「調理中の手洗い」のポイント
https://lidea.today/articles/702
コメント
全て既読にする
コメントがあるとここに表示されます